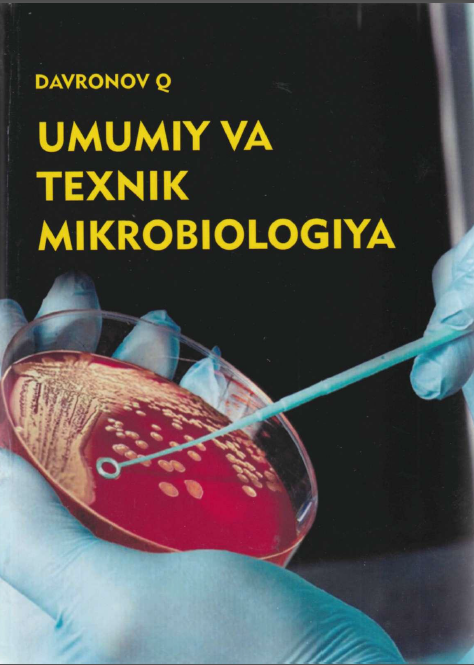

"U" Results
-

-

Umumiy psixologiya
- 2021-12-23 17:18:21
- 925 Views
- 5 Readings
-

UMUMIY PEDAGOGIKA
- 2021-12-24 13:37:02
- 745 Views
- 0 Readings
-

U M U M I Y P S I X O L O G I Y A
- 2021-12-24 13:38:41
- 856 Views
- 50 Readings
-

UMUMIY PEDAGOGIKA
- 2021-12-24 13:43:50
- 898 Views
- 0 Readings
-

UMUMIY PSIXOLOGIYA
- 2021-12-24 18:23:44
- 781 Views
- 27 Readings
-

Umumiy nisbiylik nazaryasi
- 2022-01-05 09:44:11
- 784 Views
- 0 Readings
-

Umumiylik nazaryasi
- 2022-01-07 09:59:35
- 894 Views
- 0 Readings
-

UMUMIY VA NOORGANIK KIMYODAN MASALA VA MASHQLAR TOTLAMI
- 2022-01-07 10:01:47
- 862 Views
- 0 Readings
-

UMUMIY VA NOORGANIK KIMYO
- 2022-01-07 10:04:19
- 1143 Views
- 0 Readings
-

UMUMIY PEDAGOGIKA
- 2022-01-07 10:06:37
- 851 Views
- 0 Readings
-

UMUMIY TILSHUNOSLIK fani bo`yicha O`QUV-USLUBIY MAJMUASI
- 2022-02-01 13:03:28
- 925 Views
- 0 Readings
-
Umumiy Pedagogika
- 2022-02-07 16:34:09
- 798 Views
- 1 Readings
-
UMUMIY PEDAGOGIKA
- 2022-02-07 16:35:39
- 979 Views
- 0 Readings
-
Umumiy fizika kursi
- 2022-02-08 11:42:55
- 894 Views
- 1 Readings
-
Umumiy fizika kursi. Elektr va magnetizm ()
- 2022-02-08 11:48:15
- 853 Views
- 1 Readings
-
Umumiy fizika kursi. Yadro va elementar zarralar
- 2022-02-08 12:01:07
- 934 Views
- 1 Readings
-
Usmanov gimnastika darslarida innovatsiyon texnalogiyalar
- 2022-02-09 09:52:57
- 857 Views
- 0 Readings
-
umumiy-sotsiologiya
- 2022-02-09 09:57:54
- 816 Views
- 0 Readings
-
UMUMIY PEDAGOGIKA
- 2022-02-09 10:17:41
- 769 Views
- 0 Readings
-
UMUMIY PEDAGOGIKA
- 2022-02-09 10:21:22
- 772 Views
- 0 Readings
-
UMUMIY PEDAGOGIKA
- 2022-02-09 10:23:13
- 960 Views
- 0 Readings
-
UMUMIYTABNY GEOGRAFIYA
- 2022-02-10 11:46:32
- 735 Views
- 0 Readings
-
UMUMIY EKOLOGIYA
- 2022-02-10 11:47:46
- 786 Views
- 1 Readings
-
UMUMIY TABIIY GEOGRAFIYA
- 2022-02-10 11:59:49
- 829 Views
- 7 Readings
-
Umumiy yer bilimi
- 2022-02-10 12:01:28
- 824 Views
- 5 Readings
-
Umurtqasizlar zoologiyasi
- 2022-02-10 12:08:48
- 1318 Views
- 2 Readings
-
UMUMIY PSIXOLOGIYA
- 2022-02-12 10:21:15
- 792 Views
- 1 Readings
-
Umumiy psixologiya
- 2022-02-12 10:22:56
- 751 Views
- 0 Readings
-
UMUMIY PEDAGOGIKA
- 2022-02-12 15:05:54
- 971 Views
- 10 Readings
-
USLUBIY KO`RSATMA
- 2022-04-01 12:11:10
- 889 Views
- 0 Readings
-
UMUMIY O‘RTA TA’LIMDA BIOLOGIYA FANINI O‘QITISH METODIKASI
- 2022-04-01 14:27:56
- 861 Views
- 0 Readings
-
ULARNI YECHISHGA DOIR KO‘RSATMALAR
- 2022-04-02 09:19:27
- 778 Views
- 0 Readings
-
UNDERSTANDING AND USING INGLISH GRAMMAR
- 2022-04-06 14:16:47
- 762 Views
- 0 Readings
-
UMUMIY TABIIY GEOGRAFIYA
- 2022-04-11 09:41:23
- 918 Views
- 2 Readings
-
Umumiy yer bilimi
- 2022-04-11 09:46:32
- 982 Views
- 0 Readings
-
UMUMIY GIDROLOGIYA VA IQLIMSHUNOSLIK TOSHKENT
- 2022-04-11 10:06:35
- 790 Views
- 21 Readings
-
UMUMIY TABIIY GEOGRAFIYA FANIDAN AMALIY MASHG’ULOTLAR
- 2022-04-11 10:31:18
- 919 Views
- 4 Readings
-
UMUMIY GEOLOGIYA
- 2022-04-11 13:20:36
- 834 Views
- 0 Readings
-
UMUMIY TABIIY GEOGRAFIYA
- 2022-04-11 14:36:21
- 816 Views
- 0 Readings
-
UMUMIY FIZIKA KURSIDAN MASALALAR TO'PLAMI
- 2022-04-12 10:58:57
- 1187 Views
- 0 Readings
-
Ulug'bek hayoti va faoliyati
- 2022-04-12 12:03:15
- 780 Views
- 0 Readings
-
Ulug'bek Muhammad Tarag'ay
- 2022-04-12 12:04:46
- 782 Views
- 0 Readings
-
UMUMIY GEOLOGIYA
- 2022-04-12 14:55:45
- 727 Views
- 0 Readings
-
UMUMIY YER BILIMI
- 2022-04-12 14:56:12
- 810 Views
- 0 Readings
-
UMUMIY YER BILIMI
- 2022-04-12 14:57:31
- 747 Views
- 0 Readings
-
UMUMIY VA TARIXIY GEOLOGIYA
- 2022-04-12 14:59:54
- 923 Views
- 0 Readings
-
UMUMIY TABIIY GEOGRAFIYA
- 2022-04-12 15:01:03
- 721 Views
- 0 Readings
-
Umumiy tabiiy geografiya
- 2022-04-12 15:03:04
- 695 Views
- 0 Readings
-
UMUMIY TABIIY GEOGRAFIYA
- 2022-04-12 15:03:29
- 738 Views
- 0 Readings
-
UMUMIY GEOLOGIYA
- 2022-04-12 15:04:37
- 739 Views
- 0 Readings
-
UMUMIY GEOLOGIYA
- 2022-04-12 15:06:25
- 768 Views
- 0 Readings
-
UMUMIY GEOLOGIYA
- 2022-04-12 15:06:59
- 718 Views
- 0 Readings
-
Umumiy geologiya
- 2022-04-12 15:07:07
- 724 Views
- 0 Readings
-
Ulketaniw ha`m turizm
- 2022-04-12 15:09:51
- 871 Views
- 0 Readings
-
UMUMIY VA TARIXIY GEOLOGIYA
- 2022-04-12 15:15:43
- 756 Views
- 0 Readings
-
-
ULÍWMA JER BILIMI
- 2022-04-13 09:30:47
- 753 Views
- 0 Readings
-
UMUMIY ASTRONOMIYA
- 2022-04-13 09:50:06
- 848 Views
- 0 Readings
-
UMUMIY VA TIBBIY PSIXOLOGIYA
- 2022-04-18 10:03:41
- 1624 Views
- 0 Readings
-
UMUMIY PEDAGOGIKA
- 2022-04-18 13:32:43
- 821 Views
- 0 Readings
-
UMUMIY PEDAGOGIKA
- 2022-04-18 13:35:52
- 1120 Views
- 0 Readings
-
UMUMIY PSIXOLOGIYA
- 2022-04-18 13:38:12
- 870 Views
- 5 Readings
-
UMUMIY PEDАGOGIKА
- 2022-04-18 13:38:58
- 744 Views
- 0 Readings
-
UMUMIY PEDAGOGIKA NAZARIYASI VA AMALIYOTI
- 2022-04-18 13:39:52
- 815 Views
- 0 Readings
-
-
-
UMUMTA’LIM MAKTABLARIDA XALQ HUNARMANDCHILIGINI O’RGANISH USULLARI
- 2022-04-18 13:44:01
- 763 Views
- 0 Readings
-
-
-
-
-
Umum ta’lim maktablarida musiqiy ta’limning o’ziga xos xususiyatlari.
- 2022-04-19 13:31:10
- 750 Views
- 0 Readings
-
UMUMIY PSIXOLOGIYA
- 2022-04-19 15:40:53
- 786 Views
- 5 Readings
-
-
UMUMIY FIZIKA KURSIDAN LABORATORIYA ISHLARI TO’PLAMI
- 2022-04-20 15:28:14
- 972 Views
- 0 Readings
-
UMUMIY FIZIKA KURSIDAN LABORATORIYA ISHLARI TO’PLAMI 3-qism
- 2022-04-20 15:29:39
- 730 Views
- 0 Readings
-
UMUMIY FIZIKA KURSIDAN MASALALAR TO`PLAMI ( II qism )
- 2022-04-20 15:51:28
- 794 Views
- 3 Readings
-
UMUMIY BIOLOGIYA
- 2022-04-21 10:06:54
- 934 Views
- 0 Readings
-
-
UMUMIY SOTSIOLOGIYA
- 2022-04-22 09:22:27
- 798 Views
- 0 Readings
-
UMUMIY PSIXOLOGIYA
- 2022-06-10 10:30:19
- 926 Views
- 3 Readings
-
UMUMIY KIMYO
- 2023-02-28 13:34:47
- 785 Views
- 0 Readings
-
Umumiy geologiya
- 2023-03-01 08:32:46
- 766 Views
- 0 Readings
-
UMUMIYTABNY GEOGRAFIYA
- 2023-03-01 08:35:37
- 754 Views
- 0 Readings
-
UMUMIY PEDAGOGIKA
- 2023-03-01 12:32:03
- 794 Views
- 0 Readings
-
UMUMIY PSIXODIAGNOSTIKA
- 2023-03-01 12:33:03
- 1071 Views
- 0 Readings
-
UY-JOY HUQUQI
- 2023-03-01 12:34:10
- 720 Views
- 0 Readings
-
USTAQIL O'ZBEKISTON TARIXI
- 2023-03-01 12:46:20
- 809 Views
- 0 Readings
-
UMUMIY PSIXOLOGIYA
- 2023-03-01 15:48:27
- 741 Views
- 0 Readings
-
Umumiy pedagogika nazariyasi va amaliyoti
- 2023-03-01 15:59:45
- 912 Views
- 0 Readings
-
UMUMIY SOTSIOLOGIYA
- 2023-03-02 12:47:11
- 846 Views
- 0 Readings
-
UMUMIY EKOLOGIYA FANIDAN MA’RUZALAR MATNI
- 2023-03-02 14:09:49
- 780 Views
- 0 Readings
-
UMUMIY TABIIY GEOGRAFIYA” fanidan O‘ Q U V –U S L U B I Y M A J M U A
- 2023-03-02 14:11:48
- 780 Views
- 1 Readings
-
UMUMIY SOTSIOLOGIYA
- 2023-03-02 15:31:12
- 742 Views
- 0 Readings
-
UMUMIY GEOLOGIYA
- 2023-03-02 15:36:23
- 870 Views
- 0 Readings
-
UMUMIY YER BILIMI
- 2023-03-02 15:39:51
- 803 Views
- 0 Readings
-
Umurtqasizlar_zoologiyasi
- 2023-03-02 15:41:10
- 749 Views
- 0 Readings
-
UMUMIY PEDAGOGIKA
- 2023-03-02 17:01:56
- 737 Views
- 0 Readings
-
U M U M I Y P S I X O L O G I Y A
- 2023-03-02 17:03:34
- 709 Views
- 0 Readings
-
U M U M I Y P S I X O L O G I Y A
- 2023-03-02 17:04:18
- 683 Views
- 0 Readings
-
Umumuiy pedagogika
- 2023-03-02 17:15:42
- 698 Views
- 0 Readings
-
UMUMIY KIMYO
- 2023-03-03 12:12:41
- 708 Views
- 0 Readings
-
Umumiy kimyoviy texnologiya
- 2023-03-03 12:14:14
- 803 Views
- 0 Readings
-
UMUMIY VA NOORGANIK KIMYO
- 2023-03-03 12:18:29
- 726 Views
- 0 Readings
-
UMUMIY VA NOORGANIK KIMYO 1QISM
- 2023-03-03 12:20:32
- 837 Views
- 0 Readings
-
UMUMIY YA NOORGANIK KIMYODAN MASALA YA MASHQLAR TOTLAM
- 2023-03-03 12:21:58
- 768 Views
- 0 Readings
-
UMUMIY KIMYO 1 QISM
- 2023-03-03 12:27:20
- 1136 Views
- 0 Readings
-
UMUMIY KIMYO 2QISM
- 2023-03-03 12:31:30
- 1657 Views
- 0 Readings
-
UMUMIY VA NOORGANIK KIMYO
- 2023-03-03 12:34:43
- 714 Views
- 0 Readings
-
UMUMIY GIGEYINA VA EKOLOGIYA
- 2023-03-03 12:46:47
- 808 Views
- 0 Readings
-
UMUMIY VA NOORGANIK KIMYODAN MASALA YA MASHQLAR TO‘PLAMI
- 2023-03-03 12:52:45
- 775 Views
- 0 Readings
-
UMUMIY KIMYO
- 2023-03-03 12:58:42
- 838 Views
- 0 Readings
-
UMUMIY VA NOORGANIK KIMYODAN MASALA VA MASHQLAR TOTLAMI
- 2023-03-03 13:00:24
- 783 Views
- 0 Readings
-
UMUMIY VA NOORGANIK KIMYO
- 2023-03-03 13:59:52
- 694 Views
- 0 Readings
-
UMUMIY PSIXOLOGIYA
- 2023-03-04 09:12:29
- 785 Views
- 0 Readings
-
UMUMIY PSIXOLOGIYA
- 2023-03-04 09:48:09
- 1174 Views
- 1 Readings
-
UMUMIY VA SPORT PSIXOLOGIYASI
- 2023-03-04 10:01:50
- 808 Views
- 0 Readings
-
UMUMIY PEDAGOGIKA
- 2023-03-04 10:13:41
- 681 Views
- 0 Readings
-
UMUMIY PSIXOLOGIYA
- 2023-03-04 10:51:08
- 699 Views
- 0 Readings
-
UMUMIY EKOLOGIYA
- 2023-03-04 11:07:51
- 830 Views
- 0 Readings
-
UMUMIY PEDAGOGIKA
- 2023-03-04 11:55:25
- 830 Views
- 0 Readings
-
UMUMIY PEDAGOGIKA
- 2023-03-04 11:59:27
- 798 Views
- 0 Readings
-
UMUMIY PEDAGOGIКA
- 2023-03-04 12:25:07
- 687 Views
- 0 Readings
-
UMUMIY PEDAGOGIKA
- 2023-03-04 12:39:47
- 836 Views
- 0 Readings
-
Umumiy gigiyena va ekalogiya
- 2023-03-04 14:40:57
- 880 Views
- 19 Readings
-
UMUMIY PSIXOLOGIYA
- 2023-03-04 14:43:49
- 780 Views
- 0 Readings
-
UMUMIY PSIXOLOGIYА
- 2023-03-04 14:50:26
- 869 Views
- 0 Readings
-
UMUMIY YER BILIMI
- 2023-03-04 15:51:45
- 763 Views
- 0 Readings
-
UMUMIY GEOLOGIYA
- 2023-03-04 15:51:48
- 785 Views
- 0 Readings
-
UMUMIY TABIIY GEOGRAFIYA
- 2023-03-04 15:53:08
- 773 Views
- 0 Readings
-
UMURTQASIZLAR ZOOLOGIYASIDAN LABORATORIYA MASHG‘ULOTLARI
- 2023-03-04 16:04:28
- 780 Views
- 0 Readings
-
UMUMIY PEDAGOGIKA NAZARIYASI VA AMALIYOTI
- 2023-03-04 16:36:14
- 1348 Views
- 0 Readings
-
UMUMIY VA NOORGANIK KIMYODAN MASALA VA MASHQLAR TO‘PLAMI
- 2023-03-04 17:02:51
- 806 Views
- 0 Readings
-
UMUMIY PSIXOLOGIYА
- 2023-03-06 09:39:07
- 674 Views
- 0 Readings
-
UMUMIYT
- 2023-03-06 09:40:24
- 729 Views
- 0 Readings
-
UMUMIY PSIXOLOGIYA NAZARIYASI VA AMALIYOTI
- 2023-03-06 09:41:51
- 932 Views
- 2 Readings
-
UMUMIY GEALOGIYA
- 2023-03-06 10:22:22
- 852 Views
- 0 Readings
-
UMUMIY GIDROLOGIYA VA IQLIMSHUNOSLIK
- 2023-03-06 10:24:02
- 798 Views
- 1 Readings
-
UMUMIY TABIY GEOGRAFIYA
- 2023-03-06 10:29:22
- 755 Views
- 1 Readings
-
UMUMIY VA SIPORT PISEXALOGIYASI
- 2023-03-06 10:45:45
- 793 Views
- 0 Readings
-
UMUMIY TABIIY GEOGRAFIYA
- 2023-03-06 12:50:46
- 737 Views
- 0 Readings
-
UMUMIY VA ANORGANIK KIMYO
- 2023-03-06 14:26:12
- 880 Views
- 0 Readings
-
UMUMIY FIZIKA KURSIDAN MASALALAR TOʻPLAMI
- 2023-03-06 17:15:21
- 743 Views
- 0 Readings
-
UCHISH APPARATLARI EKSPLUATATSlYASINING NAZARIY ASOSLARI
- 2023-03-09 16:35:47
- 701 Views
- 0 Readings
-
Umumiy entomologiya va zoologiya
- 2023-03-10 09:36:47
- 941 Views
- 0 Readings
-
Umumiy kimyo fanidan
- 2023-03-10 09:58:47
- 775 Views
- 0 Readings
-
UMUMIY EKOLOGIYA
- 2023-03-10 10:01:34
- 647 Views
- 0 Readings
-
UMUMIY FIZIKADAN MASALALAR TOTLAMI
- 2023-03-10 10:06:28
- 780 Views
- 0 Readings
-
Umumiy fizikadan masalalar to'plami
- 2023-03-10 10:11:58
- 791 Views
- 0 Readings
-
UMUMIY PARAZITOLOGIYA
- 2023-03-10 10:19:58
- 688 Views
- 0 Readings
-
UMUMIY PSIXOLOGIYA
- 2023-03-10 10:22:42
- 778 Views
- 0 Readings
-
UMUMIY PSIXOLOGIYA
- 2023-03-10 10:24:48
- 690 Views
- 4 Readings
-
UMUMIY PSIXOLOGIYA
- 2023-03-10 10:27:08
- 693 Views
- 1 Readings
-
Umumiy va anorganik kimyodan laboratoriya mashg'ulotlari
- 2023-03-10 10:30:33
- 751 Views
- 0 Readings
-
Umumiy va tibbiy radiobialogiya
- 2023-03-10 10:35:18
- 761 Views
- 0 Readings
-
UMUMIY YER BILIMI
- 2023-03-10 10:37:18
- 766 Views
- 0 Readings
-
UMURTQALILAR ZOOLOGIYASI Laboratoriya mashg‘ulotlari
- 2023-03-10 10:38:52
- 791 Views
- 0 Readings
-
UMUMIY PSIXOLOGIYA maruzalar matni
- 2023-03-10 15:58:43
- 1282 Views
- 0 Readings
-
UMUMIY BIOLOGIYA (EVOLUTSIYA VA EKOLOGIYA ASOSLARI)
- 2023-03-11 09:24:28
- 811 Views
- 0 Readings
-
Umumiy va tibbiy radiobiologiya
- 2023-03-11 09:26:03
- 681 Views
- 0 Readings
-
Übungsgrammatik Deutsch als Fremdsprache
- 2023-03-11 11:33:58
- 704 Views
- 0 Readings
-
UMUMIY PSIXOLOGIYA
- 2023-03-11 11:36:42
- 893 Views
- 1 Readings
-
UMUMIY PSIXOLOGIYA
- 2023-03-11 11:48:46
- 714 Views
- 0 Readings
-
UMUMIY PSIXOLOGIYA
- 2023-03-11 12:00:39
- 782 Views
- 0 Readings
-
Umumiy ekologiya
- 2023-03-11 14:01:06
- 722 Views
- 0 Readings
-
Umumiy psixologiya
- 2023-03-11 14:02:09
- 849 Views
- 1 Readings
-
Umumiy psixologiya
- 2023-03-11 14:03:11
- 723 Views
- 0 Readings
-
Umumiy psixologiya
- 2023-03-11 14:04:33
- 949 Views
- 14 Readings
-
Umumiy psixologiya.
- 2023-03-11 14:05:46
- 1139 Views
- 4 Readings
-
Ustaxonada amaliy mashg`ulot
- 2023-03-11 14:06:49
- 1159 Views
- 0 Readings
-
UMUMIYTABNY GEOGRAFIYA
- 2023-03-11 14:36:34
- 719 Views
- 0 Readings
-
UMUMIY MIKROBIOLOGIYA
- 2023-03-11 15:52:13
- 912 Views
- 0 Readings
-
Umumiy va tibbiy radiobiologiya
- 2023-03-11 16:03:00
- 825 Views
- 0 Readings
-
UMUMIY TABIIY GEOGRAFIYA
- 2023-03-11 16:36:03
- 717 Views
- 0 Readings
-
UMUMIY VA TIBBIY RADIOBIOLOGIYA
- 2023-03-13 09:23:01
- 766 Views
- 0 Readings
-
UMUMIY PSIXOLOGIYA
- 2023-03-13 10:09:54
- 688 Views
- 2 Readings
-
UMUMIY PSIXOLOGIYA
- 2023-03-13 10:10:45
- 863 Views
- 1 Readings
-
UMUMIY MIKROBIOLOGIYA
- 2023-03-13 10:15:59
- 791 Views
- 0 Readings
-
UMUMIY VA TEXNIK MIKROBIOLOGIYA
- 2023-03-13 10:17:42
- 735 Views
- 0 Readings
-
-
UMUMIY TABIIY GEOGRAFIYA
- 2023-03-13 10:39:46
- 846 Views
- 0 Readings
-
UMUMIY FIZIKADAN MASALALAR TO‘PLAMI
- 2023-03-13 11:22:07
- 830 Views
- 0 Readings
-
UMUMIY FIZIKADAN laboratoriya ishlari
- 2023-03-16 10:46:37
- 813 Views
- 0 Readings
-
UMUMIY FIZIKADAN MASALALAR TO‘PLAMI
- 2023-03-16 10:48:29
- 804 Views
- 0 Readings
-
UMUMIY PSIXOLOGIYA
- 2023-03-16 10:49:08
- 711 Views
- 1 Readings
-
UGLEVODORODLI GAZLARNI KIMYOVIY QAYTAISHLASH TEXNOLOGIYASI
- 2023-03-16 11:52:41
- 1043 Views
- 0 Readings
-
-
UMUMIY PSIXOLOGIYA
- 2023-03-16 11:59:13
- 723 Views
- 1 Readings
-
UMUMIY VA ANORGANIK KIMYODAN LABORATORIYA MASHG'ULOTLAR
- 2023-03-16 12:01:22
- 918 Views
- 0 Readings
-
UMUMIY YA NOORGANIK KIMYODAN MASALA YA MASHQLAR TO‘PLAMI
- 2023-03-16 12:03:20
- 819 Views
- 0 Readings
-
UMUMIY VA NOORGANIK KIMYODAN MASALALAR VA ULARNI YECHISH USULLARI
- 2023-03-16 12:06:19
- 836 Views
- 0 Readings
-
UMUMIY FIZIKA KURSIDAN HISOB- CRAFIKAISHLARI
- 2023-03-23 11:36:14
- 740 Views
- 0 Readings
-
-
UMUMIY FIZIKA KURSIDAN MASALALAR TO'PLAMI
- 2023-03-23 11:38:38
- 729 Views
- 0 Readings
-
Umumiy fizika kursidan praktikum molekular fizikasi
- 2023-03-23 11:53:37
- 880 Views
- 0 Readings
-
UMUMIY FIZIKA KURSIDAN PRAKTIKUM
- 2023-03-23 11:54:49
- 822 Views
- 0 Readings
-
UMUMIY FIZIKA
- 2023-03-23 11:55:57
- 771 Views
- 0 Readings
-
UMUMIY O‘RTA TA’LIM MAKTABLARIDA TOVUSH HODISALARINI O‘QITISH
- 2023-03-23 11:56:47
- 789 Views
- 0 Readings
-
UMUMIY TILSHUNOSLIK
- 2023-03-24 11:41:17
- 1213 Views
- 0 Readings
-
Umumiy fizikadan laboratoriya ishlari
- 2023-03-24 12:57:40
- 858 Views
- 0 Readings
-
-
Umumiy nisbiylik nazariyasi
- 2023-03-24 13:00:35
- 825 Views
- 0 Readings
-
Umumiy fizika kursi (mexanika)
- 2023-03-24 15:38:38
- 829 Views
- 0 Readings
-
UCHISH APPARATLARINING EKSPLUATATSIYASI NAZARIY ASOSLARI
- 2023-03-27 13:36:18
- 727 Views
- 0 Readings
-
UMUMIY ASTRANOMIYA
- 2023-03-28 12:07:43
- 738 Views
- 0 Readings
-
Umumiy astronomiyadan laboratoriya ishlari
- 2023-03-28 12:14:05
- 828 Views
- 0 Readings
-
UMUMIY ASTRONOMIYA
- 2023-03-28 13:20:24
- 760 Views
- 0 Readings
-
UMUMIY ASTRONOMIYA
- 2023-03-28 13:21:58
- 773 Views
- 0 Readings
-
UMUMIY ASTRONOMIYA
- 2023-03-28 14:05:03
- 787 Views
- 0 Readings
-
-
UMUMIY TABIIY GEOGRAFIYA
- 2023-03-30 11:26:44
- 800 Views
- 0 Readings
-
UMUMIY TABIIY GEOGRAFIYA
- 2023-03-30 12:49:09
- 746 Views
- 0 Readings
-
UMUMIY TABIIY GEOGRAFIYA
- 2023-03-30 13:04:03
- 735 Views
- 1 Readings
-
Unified Optical Scanning Technology
- 2023-03-31 15:29:00
- 754 Views
- 0 Readings
-

Umumiy pedagogika
- 2023-10-04 10:01:07
- 780 Views
- 0 Readings
-

-

Umumiy pedagogika 1-qism
- 2023-11-30 16:33:20
- 1641 Views
- 0 Readings
-

Umumiy pedagogika nazariyasi va amaliyoti
- 2023-11-30 16:43:02
- 1250 Views
- 2 Readings
-

Uzluksiz ta`lim pedagogikasi va inklyuziv ta`lim
- 2023-11-30 16:49:36
- 1137 Views
- 0 Readings
-

Umumiy pedagogika
- 2023-11-30 17:12:34
- 911 Views
- 1 Readings
-

Umumiy pedagogika
- 2023-11-30 17:20:07
- 771 Views
- 2 Readings
-

Umumiy pedagogika
- 2023-11-30 17:21:52
- 1030 Views
- 0 Readings
-
1701347224.jpg)
Umumiy pedagogika
- 2023-11-30 17:27:04
- 1070 Views
- 0 Readings
-
-
Umumiy psixologiya
- 2024-01-20 11:43:43
- 891 Views
- 1 Readings
-
Umumiy psixologiya
- 2024-01-20 11:50:27
- 1011 Views
- 0 Readings
-

Umumiy fizika (Atom, yadro va elemtar zarralar fizikasi)
- 2024-05-28 10:48:19
- 1023 Views
- 1 Readings
-

Umumiy pedagogika nazariyasi va amaliyoti
- 2024-06-26 15:10:55
- 1022 Views
- 0 Readings
-

-

-

Umumiy pedagogika nazariyasi va amaliyoti
- 2024-07-17 10:42:45
- 769 Views
- 0 Readings
-

Umumiy pedagogika
- 2024-07-19 15:00:00
- 935 Views
- 0 Readings
-

Umumiy tabiiy geografiya
- 2024-07-22 16:33:43
- 913 Views
- 1 Readings
-

Umumiy geologiya
- 2024-07-23 10:07:56
- 931 Views
- 0 Readings
-

Umumiy psixologiya
- 2024-07-27 10:20:26
- 1312 Views
- 9 Readings
-

-

Umumiy va anorganik kimyo
- 2024-08-17 11:29:59
- 695 Views
- 0 Readings
-

Umumiy va noorganik kimyo
- 2024-08-19 14:59:17
- 887 Views
- 0 Readings
-

-

UMUMIY MIKROBILOGIYA
- 2024-08-28 15:45:10
- 786 Views
- 0 Readings
-

Umumiy pedagogika
- 2024-09-04 10:15:49
- 682 Views
- 0 Readings
-

Umumiy pedagogika I-qism
- 2024-09-04 11:11:33
- 659 Views
- 0 Readings
-

Umumiy pedagogika II-qism
- 2024-09-04 12:10:56
- 772 Views
- 1 Readings
-

Umumiy pedagogika
- 2024-09-07 09:44:54
- 592 Views
- 0 Readings
-

Umumiy pedagogika
- 2024-09-09 15:23:59
- 727 Views
- 0 Readings
-

Umumiy pedagogika
- 2024-09-10 10:17:14
- 1113 Views
- 23 Readings
-

Umumiy psixologiya
- 2024-09-10 16:39:59
- 1099 Views
- 2 Readings
-

Umumiy pedagogika 1-qism
- 2024-09-10 16:46:40
- 928 Views
- 3 Readings
-

Ulıwma pedagogika
- 2024-09-11 10:58:00
- 731 Views
- 0 Readings
-

Umumiy pedagogika
- 2024-09-11 11:33:51
- 711 Views
- 0 Readings
-

Umumiy pedagogika
- 2024-09-11 15:20:35
- 574 Views
- 0 Readings
-

Umumiy pedagogika (pedagogik mahorat)
- 2024-09-11 15:38:06
- 942 Views
- 0 Readings
-

-

Umumiy pedagogika
- 2024-09-14 10:21:55
- 678 Views
- 0 Readings
-

UMUMIY PEDAGOGIKA
- 2024-09-14 10:36:15
- 849 Views
- 0 Readings
-

Umumiy pedagogika (Pedagogika tarixi)
- 2024-09-16 09:05:02
- 554 Views
- 0 Readings
-

Undergraduate study. Book
- 2024-09-18 11:06:52
- 718 Views
- 0 Readings
-

Umumiy fizika (Atom, yadro va elemtar zarralar fizikasi)
- 2024-09-18 15:04:39
- 911 Views
- 0 Readings
-

UMUMIY FIZIKA (MEXANIKA VA MOLEKULYAR FIZIKADAN MASALALAR YECHISH)
- 2024-09-18 16:14:23
- 766 Views
- 0 Readings
-

Umumiy pedagogika
- 2024-09-19 09:28:50
- 543 Views
- 0 Readings
-

Umumiy pedagogika
- 2024-09-20 12:03:15
- 1486 Views
- 0 Readings
-

-

-

Umumiy psixologiya
- 2024-09-23 11:23:34
- 649 Views
- 1 Readings
-

Urug`lik paxta va chigitni ishlash texnologiyasi
- 2024-09-23 15:37:31
- 798 Views
- 0 Readings
-

Umumiy psixologiya
- 2024-09-24 10:04:11
- 742 Views
- 1 Readings
-

Umumiy pedagogika 1-qism
- 2024-09-27 15:09:18
- 583 Views
- 0 Readings
-

Umumiy pedagogika nazariyasi va amaliyoti
- 2024-09-30 12:00:22
- 1044 Views
- 0 Readings
-

Umumiy pedagogika 1-qism
- 2024-10-02 10:22:22
- 550 Views
- 0 Readings
-

UNIVERSUM: ХИМИЯ И БИОЛОГИЯ
- 2024-10-03 15:21:54
- 764 Views
- 0 Readings
-

Umumiy pedagogika
- 2024-10-11 16:39:49
- 591 Views
- 0 Readings
-

Umumiy kimyo fanidan laboratoriya mashg`ulotlari
- 2024-10-15 11:42:50
- 850 Views
- 0 Readings
-

Umumiy pedogogika
- 2024-10-18 09:51:31
- 710 Views
- 0 Readings
-

Umumiy pedagogika nazariyasi va amaliyoti
- 2024-10-25 15:14:05
- 793 Views
- 2 Readings
-

Umumiy va sport psixologiyasi
- 2024-10-31 11:12:23
- 761 Views
- 0 Readings
-

Umumiy kimyoviy texnologiya
- 2024-11-05 10:46:09
- 728 Views
- 0 Readings
-

-

-

-

-

Umumiy pedagogika
- 2024-11-20 14:49:58
- 612 Views
- 0 Readings
-

Umumiy pedagogika
- 2024-11-20 14:53:13
- 836 Views
- 0 Readings
-

Umumiy tabiiy geografiya
- 2024-11-22 10:54:51
- 562 Views
- 0 Readings
-

UMUMIY VA ANORGANIK KIMYO ASOSLARI
- 2024-11-26 16:26:53
- 746 Views
- 0 Readings
-

Uglevodlar va lipidlar kimyosiga kirish
- 2024-11-26 16:31:08
- 578 Views
- 0 Readings
-

Umumiy fizika
- 2024-11-27 09:56:16
- 560 Views
- 0 Readings
-

Umumiy mikrobiologiya
- 2024-11-30 12:13:42
- 743 Views
- 0 Readings
-

Unutilmas ohanglar
- 2024-12-02 10:47:26
- 725 Views
- 0 Readings
-

Umumiy va noorganik kimyo
- 2024-12-05 09:58:14
- 765 Views
- 0 Readings
-

Umumiy va noorganik kimyo fanidan laboratoriya mashg`ulotlari
- 2024-12-06 14:40:37
- 598 Views
- 0 Readings
-

UMUMIY VA ANORGANIK KIMYO
- 2024-12-06 14:53:19
- 651 Views
- 0 Readings
-

UMUMIY VA ANORGANIK KIMYODAN AMALIY VA LABORATORIYA MASHG‘ULOTLARI
- 2024-12-07 10:04:22
- 677 Views
- 0 Readings
-

UMOMIY PSIXOLOGIYA
- 2024-12-25 15:37:08
- 501 Views
- 0 Readings
-

Umumiy pedagogika nazariyasi va amaliyoti
- 2024-12-25 15:45:07
- 597 Views
- 1 Readings
-

Umumiy va noorganik kimyo
- 2024-12-25 15:56:27
- 1039 Views
- 0 Readings
-

Umumiy Pedagogika
- 2024-12-25 16:03:55
- 599 Views
- 0 Readings
-

Umumiy pedagogika
- 2024-12-25 16:23:05
- 607 Views
- 0 Readings
-

Umumiy pedagogika va psixologiya
- 2025-01-06 13:31:05
- 586 Views
- 0 Readings
-

Umumiy pedagogika va psixologiya
- 2025-01-06 14:03:16
- 592 Views
- 0 Readings
-

Umumiy psixologiya
- 2025-01-06 14:35:24
- 1054 Views
- 1 Readings
-

Umumiy psixologiya
- 2025-01-07 12:04:24
- 698 Views
- 5 Readings
-

Ulıwma psixologiya
- 2025-01-07 14:05:38
- 604 Views
- 0 Readings
-

Ulıwma hám medicinalıq psixologiya
- 2025-01-07 14:18:59
- 619 Views
- 0 Readings
-

Umumiy tabiiy geografiya
- 2025-01-08 14:52:28
- 658 Views
- 1 Readings
-

Umumiy tabiiy geografiyasi
- 2025-01-09 15:47:36
- 540 Views
- 0 Readings
-

Umumiy tabiiy geografiya
- 2025-01-09 15:50:08
- 516 Views
- 0 Readings
-

-

Umumiy va tibbiy radiobiologiya
- 2025-01-16 10:50:24
- 742 Views
- 0 Readings
-

Umumiy psixologiya fanidan uslubiy metodik qo`llanma
- 2025-01-16 11:02:34
- 1140 Views
- 1 Readings
-

Umumiy psixologiya
- 2025-01-16 11:16:45
- 888 Views
- 9 Readings
-

Umumiy biologiya
- 2025-01-17 09:52:05
- 743 Views
- 0 Readings
-

UMUMIY PEDAGOGIKA (Tarbiya nazariyasi)
- 2025-01-18 08:33:00
- 694 Views
- 0 Readings
-

-

Umurtqasizlar zoologiyasi
- 2025-01-23 09:38:30
- 765 Views
- 0 Readings
-

Umumiy pedagogika
- 2025-01-23 09:39:26
- 634 Views
- 0 Readings
-

Umumiy pedagogika nazariyasi va amaliyoti
- 2025-01-23 09:52:49
- 671 Views
- 0 Readings
-

Umumiy fizikadan laboratoriya ishlari
- 2025-01-24 09:16:29
- 1358 Views
- 0 Readings
-

Umumiy fizikadan masalalar to’plami
- 2025-01-24 14:35:01
- 818 Views
- 0 Readings
-

Umumiy fortepiano
- 2025-01-27 14:51:41
- 719 Views
- 0 Readings
-

Ustoz toridagi sadolar (Komiljon Otaniyozov ijodidan saylanma)
- 2025-01-27 16:01:03
- 567 Views
- 0 Readings
-

UMUMIY PEDAGOGIKA (Tarbiya nazariyasi)
- 2025-01-28 10:05:21
- 617 Views
- 0 Readings
-

Umumiy pedagogika
- 2025-01-28 10:12:36
- 729 Views
- 0 Readings
-

Umumiy pedagogika (II qism)
- 2025-01-28 10:33:38
- 675 Views
- 0 Readings
-

Umumiy pedagogika va psixologiya. 1-qism
- 2025-01-28 10:38:28
- 637 Views
- 0 Readings
-

Umumiy pedagogika va psixologiya
- 2025-01-28 14:37:44
- 586 Views
- 0 Readings
-

Umumiy pedagogika
- 2025-01-28 14:41:09
- 687 Views
- 0 Readings
-

Umumiy pedagogika
- 2025-01-28 14:44:23
- 628 Views
- 0 Readings
-

Umumiy pedagogika
- 2025-01-28 14:45:55
- 702 Views
- 0 Readings
-

Umumiy pedagogika nazariyasi va amaliyoti
- 2025-01-28 14:55:43
- 738 Views
- 0 Readings
-

Umumiy pedagogika
- 2025-01-28 15:43:54
- 650 Views
- 0 Readings
-

Umumiy pedagogika II-qism
- 2025-01-29 10:11:43
- 567 Views
- 0 Readings
-

Umumiy pedagogika
- 2025-01-30 10:22:39
- 823 Views
- 0 Readings
-

Umumiy pedagogika
- 2025-01-30 10:38:10
- 629 Views
- 0 Readings
-

Umumiy pedagogika
- 2025-01-31 10:23:30
- 515 Views
- 0 Readings
-

UMUMIY PEDAGOGIKA NAZARIYASI VA AMALIYOTI
- 2025-01-31 10:32:47
- 747 Views
- 0 Readings
-

Umumiy pedagogika
- 2025-02-05 10:59:58
- 832 Views
- 0 Readings
-

UMUMIY PEDAGOGIKA (Tarbiya nazariyasi)
- 2025-02-06 16:39:29
- 612 Views
- 0 Readings
-

-

Umumiy pedagogika
- 2025-02-07 14:57:50
- 753 Views
- 0 Readings
-

Umumiy pedagogika nazariyasi va amaliyoti
- 2025-02-07 14:58:46
- 559 Views
- 0 Readings
-

UMUMIY PEDAGOGIKA
- 2025-02-07 15:14:07
- 719 Views
- 0 Readings
-

Uydagi yakka tartibdagi ta'lim
- 2025-02-08 09:04:17
- 636 Views
- 0 Readings
-

Umumiy pedagogika.1 qism
- 2025-02-08 14:17:21
- 726 Views
- 0 Readings
-

ÚZLIKSIZ TÁLIM PEDAGOGIKASİ
- 2025-02-08 14:25:04
- 644 Views
- 0 Readings
-

Umumiy pedagogika
- 2025-02-10 10:54:58
- 729 Views
- 0 Readings
-

Umumiy pedagogika (pedagogika nazariyasi)
- 2025-02-10 10:57:10
- 621 Views
- 0 Readings
-

umumiy pedagogika
- 2025-02-10 11:00:08
- 606 Views
- 0 Readings
-

Umumsan'at tarixi
- 2025-02-11 09:52:39
- 582 Views
- 0 Readings
-

Umumiy pedagogika.I qism
- 2025-02-11 10:03:40
- 608 Views
- 0 Readings
-

Umumiy pedagogika va psixologiya
- 2025-02-11 10:22:30
- 591 Views
- 0 Readings
-

Umumiy pedagogika
- 2025-02-11 10:48:56
- 515 Views
- 0 Readings
-

Umumiy pedagogika
- 2025-02-11 14:26:46
- 497 Views
- 0 Readings
-

UMUMIY PEDAGOGIKA
- 2025-02-12 15:43:10
- 728 Views
- 0 Readings
-

Umumiy pedagogika
- 2025-02-12 16:15:47
- 561 Views
- 0 Readings
-

Umumiy pedagogika
- 2025-02-12 16:59:44
- 666 Views
- 0 Readings
-

Umumiy pedagogika (Pedagogik mahorat)
- 2025-02-13 09:04:57
- 474 Views
- 0 Readings
-

Umumiy pedagogika
- 2025-02-13 09:11:31
- 789 Views
- 0 Readings
-

Umumiy pedagogika
- 2025-02-13 14:06:29
- 557 Views
- 0 Readings
-

Umumiy pedagogika (Pedagogika tarixi)
- 2025-02-13 14:15:02
- 535 Views
- 2 Readings
-

Umumiy pedagogika
- 2025-02-14 10:37:56
- 642 Views
- 0 Readings
-

-
Umumiy va texnik mikrobiologiya
- 2025-02-18 10:25:43
- 525 Views
- 0 Readings
-

-

Understanding Psychology
- 2025-02-20 09:20:21
- 644 Views
- 0 Readings
-

Understanding Psychology
- 2025-02-20 09:28:10
- 703 Views
- 0 Readings
-

Uzliksiz ta'lim tizimida davlat ta'lim standartlari
- 2025-02-20 09:43:34
- 659 Views
- 0 Readings
-

Umumta'lim maktablarida inshoni tashkil etish usullari
- 2025-02-21 11:05:05
- 695 Views
- 0 Readings
-

Umumta'lim maktablarida aruz tizimini o'qitish muammolari
- 2025-02-21 16:44:55
- 638 Views
- 0 Readings
-

Umumiy tabiiy geografiya
- 2025-02-26 11:41:16
- 461 Views
- 0 Readings
-

Umumiy tabiiy geografiya
- 2025-02-26 11:46:13
- 746 Views
- 0 Readings
-

Umumiy parazitologiya
- 2025-03-03 16:43:35
- 542 Views
- 0 Readings
-

Umumiy psixologiya
- 2025-04-09 09:54:45
- 550 Views
- 1 Readings
-

Ustrushonaning qadimgi davrdagi etnik tarixi
- 2025-04-10 11:37:51
- 528 Views
- 0 Readings
-

Umumiy tilshunoslik (amaliy tilshunoslik)
- 2025-04-12 10:35:43
- 665 Views
- 0 Readings
-
Unser Alltag
- 2025-04-15 10:34:26
- 529 Views
- 0 Readings
-
Unter Turmen und Masten.
- 2025-04-18 09:25:17
- 592 Views
- 0 Readings
-

Umumiy pedagogika
- 2025-04-19 11:04:55
- 676 Views
- 3 Readings
-

Umumta'lim va maxsus fanlarning o'zaro aloqadorligini ta'minlash.
- 2025-04-19 11:19:39
- 804 Views
- 0 Readings
-

-

Ulıwma pedagogika (2-modul. Pedagogika tariyxı)
- 2025-04-26 09:51:37
- 764 Views
- 0 Readings
-

-

UMUMIY YER BILIMI
- 2025-05-06 14:36:31
- 525 Views
- 0 Readings
-

Umumiy pedagogika. Pedagogik mahorat
- 2025-05-22 10:21:40
- 580 Views
- 0 Readings
-

UZLIKSIZ TA'LIM PEDAGOGIKASİ
- 2025-05-23 09:27:05
- 651 Views
- 0 Readings
-

Umumiy o'rta ta'lim fizika kursining metodologik masalalari
- 2025-05-23 09:50:49
- 607 Views
- 0 Readings
-

Umumta'lim maktablarida inshoni tashkil etish usullari
- 2025-05-24 09:46:05
- 618 Views
- 0 Readings
-

Uydagi yakka tartibdagi ta'lim
- 2025-05-24 14:38:05
- 434 Views
- 0 Readings
-

Umumiy pedagogika
- 2025-05-30 09:50:25
- 620 Views
- 3 Readings
-

Umumiy tabiiy geografiya
- 2025-06-02 09:14:54
- 626 Views
- 1 Readings
-

Umumiy fizika
- 2025-06-04 10:59:44
- 567 Views
- 0 Readings
-

Umumiy mikrobiologiya fanidan laboratoriya mashg`ulotlari
- 2025-06-11 16:14:39
- 633 Views
- 0 Readings
-

Ustrushonaning qadimgi davridagi etnogenetik jarayonlar
- 2025-06-16 11:01:12
- 619 Views
- 0 Readings
-

Umumta'lim maktablarida aruz tizimini o'qitish muammolari
- 2025-06-27 16:01:30
- 467 Views
- 0 Readings
-

-

Umumiy kimyoviy texnologiya
- 2025-07-29 09:37:38
- 407 Views
- 0 Readings
-

Umumiy noorganik kimyo. 1-qism
- 2025-07-29 11:35:52
- 807 Views
- 0 Readings
-

UMUMIY FIZIKA
- 2025-08-06 16:16:39
- 536 Views
- 0 Readings
-

Umumiy fizika Optika
- 2025-08-06 16:26:46
- 474 Views
- 0 Readings
-

Ulíwma psixologiya
- 2025-08-08 11:01:11
- 488 Views
- 0 Readings
-

Umumiy pedagogika (Pedagogika tarixi)
- 2025-08-15 11:20:35
- 453 Views
- 0 Readings
-

Umumiy psixologiya 1-kitob
- 2025-08-21 13:10:33
- 463 Views
- 1 Readings
-

Umumiy fizika kursidan praktikum. Mexanika
- 2025-08-21 13:12:29
- 462 Views
- 0 Readings
-

Umumiy psixologiya
- 2025-08-21 13:13:43
- 394 Views
- 1 Readings
-

Umumiy pedagogika
- 2025-08-21 13:15:57
- 481 Views
- 0 Readings
-

Umumiy psixologiya
- 2025-08-21 13:17:58
- 446 Views
- 0 Readings
-

Umumiy pedagogika
- 2025-08-21 13:21:04
- 432 Views
- 0 Readings
-

Umumiy pedagogika
- 2025-08-21 13:27:51
- 428 Views
- 0 Readings
-

Umumiy pedagogika
- 2025-08-21 13:31:22
- 437 Views
- 0 Readings
-

Umumiy pedagogikadan amaliy mashg`ulotlar (didaktika)
- 2025-08-21 13:33:24
- 448 Views
- 0 Readings
-

Umumiy pedagogika (Pedagogika tarixi)
- 2025-08-21 13:34:22
- 418 Views
- 0 Readings
-

UMUMIY MIKROBIOLOGIYA
- 2025-08-21 13:35:38
- 488 Views
- 0 Readings
-

Umumiy kimyoviy texnologiya
- 2025-08-21 13:44:51
- 454 Views
- 0 Readings
-

UMUMIY PSIXOLOGIYA
- 2025-08-21 14:01:18
- 455 Views
- 0 Readings
-

Umumiy fizika
- 2025-08-21 14:03:38
- 401 Views
- 0 Readings
-

UMUMIY ASTRONOMIYA
- 2025-08-21 14:05:55
- 415 Views
- 0 Readings
-

Umumiy kimyo fanidan laboratoriya mashg`ulotlari
- 2025-08-21 14:25:20
- 446 Views
- 0 Readings
-

Umumiy fizika
- 2025-08-21 14:37:52
- 469 Views
- 0 Readings
-

Umumiy kimyodan amaliy mashg`ulotlar
- 2025-08-21 14:45:13
- 562 Views
- 0 Readings
-

Umumiy fizika Optika
- 2025-08-21 15:07:35
- 451 Views
- 0 Readings
-

Umumiy pedagogika va psixologiya
- 2025-08-21 15:59:05
- 455 Views
- 0 Readings
-

Umumiy fizika kursining “MEXANIKA”
- 2025-08-21 16:00:27
- 441 Views
- 0 Readings
-

Umumiy pedagogika
- 2025-08-21 16:02:12
- 462 Views
- 0 Readings
-

Umumiy pedagogika
- 2025-08-22 09:32:35
- 435 Views
- 0 Readings
-

Umumiy psixologiya
- 2025-08-22 09:35:09
- 522 Views
- 1 Readings
-

UMUMIY PEDAGOGIKA NAZARIYASI VA AMALIYOTI
- 2025-08-22 09:36:58
- 493 Views
- 0 Readings
-

UMUMIY PSIXOLOGIYA
- 2025-08-22 09:40:35
- 470 Views
- 1 Readings
-

Umumiy fizika
- 2025-08-22 09:43:34
- 428 Views
- 0 Readings
-

Umumiy pedagogika
- 2025-08-22 09:57:10
- 486 Views
- 0 Readings
-

Umumiy pedagogika
- 2025-08-22 09:59:12
- 463 Views
- 0 Readings
-

Umumiy psixologiya
- 2025-08-22 10:01:52
- 542 Views
- 2 Readings
-

Umumiy psixоlоgiyа
- 2025-08-22 10:05:03
- 611 Views
- 0 Readings
-

Umumiy va tibbiy radiobiologiya
- 2025-08-22 10:40:56
- 463 Views
- 0 Readings
-

Umumiy psixologiya
- 2025-08-22 10:46:42
- 421 Views
- 1 Readings
-
Umumiy va sport psixologiyasi
- 2025-08-22 11:02:29
- 448 Views
- 0 Readings
-
Umumiy psixologiya
- 2025-08-22 11:06:21
- 420 Views
- 1 Readings
-

Umumiy pedagogika.
- 2025-08-22 17:15:43
- 462 Views
- 0 Readings
-

Umumiy psixologiya
- 2025-08-23 09:31:06
- 409 Views
- 1 Readings
-

Umumiy gidrologiya va iqlimshunoslik
- 2025-08-23 09:34:04
- 395 Views
- 0 Readings
-

Umumiy psixologiya
- 2025-08-23 09:47:34
- 383 Views
- 1 Readings
-

Umumiy pedagogika
- 2025-08-23 09:58:38
- 435 Views
- 0 Readings
-

Umumiy pedagogika
- 2025-08-23 10:03:21
- 391 Views
- 0 Readings
-

Umumiy parazitologiya
- 2025-08-23 10:38:33
- 651 Views
- 0 Readings
-

UMUMIY PSIXOLOGIYA
- 2025-08-23 10:49:14
- 414 Views
- 1 Readings
-

Umumiy va anorganik kimyo
- 2025-08-23 10:52:28
- 457 Views
- 0 Readings
-

Umumiy tabiiy geografiya
- 2025-08-23 10:55:25
- 528 Views
- 0 Readings
-

Umumiy Tilshunoslik
- 2025-08-23 11:03:15
- 501 Views
- 0 Readings
-

Umumiy pedagogika nazariyasi va amakbyoti
- 2025-08-23 11:35:26
- 455 Views
- 0 Readings
-

Umumiy fizikaning optika bo`limdan masalalar to`plami
- 2025-08-23 11:37:27
- 422 Views
- 0 Readings
-

UMUMIY PEDAGOGIKA
- 2025-08-23 11:40:31
- 544 Views
- 0 Readings
-

Umumiy pedagogika
- 2025-08-25 09:40:25
- 449 Views
- 0 Readings
-

Umumiy psixologiya
- 2025-08-25 10:04:26
- 379 Views
- 1 Readings
-

Umumiy psixologiya
- 2025-08-25 10:25:41
- 404 Views
- 1 Readings
-

Umumiy pedagogika
- 2025-08-25 11:21:51
- 414 Views
- 0 Readings
-

Umumiy tabiiy geograflya
- 2025-08-25 15:21:32
- 443 Views
- 0 Readings
-

Umumiy fortepiano
- 2025-08-25 15:35:49
- 513 Views
- 0 Readings
-

Umumiy psixologiya
- 2025-08-25 15:38:28
- 576 Views
- 0 Readings
-

Umumiy gidrologiya
- 2025-08-25 15:40:06
- 622 Views
- 0 Readings
-

Umumiy va tarixiy geologiya
- 2025-08-25 15:43:16
- 618 Views
- 0 Readings
-

Umumiy psixalogiya
- 2025-08-25 15:47:19
- 600 Views
- 0 Readings
-

Umumiy fizikadan masalalar to‘plami
- 2025-08-25 16:08:47
- 599 Views
- 0 Readings
-

Umumiy fizika kursidan praktikum. Mexanika
- 2025-08-25 16:11:16
- 504 Views
- 0 Readings
-

Umumiy mikrоbiоlоgiya
- 2025-08-26 09:36:11
- 410 Views
- 0 Readings
-

Umumiy didaktika
- 2025-08-26 09:39:14
- 734 Views
- 0 Readings
-

Umumiy tabiiy geografiya
- 2025-08-26 09:42:02
- 422 Views
- 0 Readings
-

Umumiy toksikologiya
- 2025-08-26 09:49:05
- 441 Views
- 0 Readings
-

Umumiy tabiiy geografiya
- 2025-08-28 14:53:02
- 478 Views
- 0 Readings
-

Umumiy elektrotexnika va elektronika asoslari
- 2025-08-29 15:17:32
- 473 Views
- 0 Readings
-

-

Umumiy tilshunoslik (amaliy tilshunoslik)
- 2025-09-08 16:08:53
- 426 Views
- 0 Readings
-

UNLOCK reading 8 writing skills.
- 2025-09-17 11:33:06
- 397 Views
- 0 Readings
-

Umumiy fizikadan masalalar to'plami
- 2025-09-23 11:17:19
- 565 Views
- 0 Readings
-

Umumiy va noorganik kimyodan amaliy mashg`ulotlar
- 2025-09-30 11:12:26
- 335 Views
- 0 Readings
-

UZLIKSIZ TA'LIM PEDAGOGIKASİ
- 2025-10-09 11:12:11
- 363 Views
- 0 Readings
-

Umumiy pedagogika
- 2025-10-09 15:10:47
- 330 Views
- 0 Readings
-

Umumiy pedagogika
- 2025-10-09 15:35:30
- 341 Views
- 0 Readings
-

Umumiy Tilshunoslik
- 2025-10-25 10:28:55
- 394 Views
- 0 Readings
-

Umumiy tilshunoslik
- 2025-10-28 09:33:52
- 362 Views
- 0 Readings
-

Ulıwma psixologiya
- 2025-10-31 10:06:45
- 342 Views
- 0 Readings
-

-
UMURTQALILAR ZOOLOGIYASI
- 2025-11-11 14:45:35
- 417 Views
- 0 Readings
-
UMURTQALILAR ZOOLOGIYASI
- 2025-11-12 10:24:27
- 402 Views
- 0 Readings
-
UMURTQASIZLAR ZOOLOGIYASI
- 2025-11-12 10:58:47
- 325 Views
- 0 Readings
-

Úzliksiz tálim pedagogikasi
- 2025-11-12 10:59:53
- 443 Views
- 0 Readings
-
UMURTQALILAR ZOOLOGIYASI
- 2025-11-13 10:13:35
- 345 Views
- 0 Readings
-
UMURTQALILAR ZOOLOGIYASI Laboratoriya mashg‘ulotlari
- 2025-11-13 15:32:58
- 419 Views
- 0 Readings
-

Umumta'lim maktablarida aruz tizimini o'qitish muammolari
- 2025-11-17 16:11:35
- 349 Views
- 0 Readings
-
UMURTQALILAR ZOOLOGIYASI
- 2025-11-19 10:25:45
- 324 Views
- 0 Readings
-
UZLIKSIZ TA'LIM PEDAGOGIKASİ
- 2025-11-22 10:23:12
- 317 Views
- 0 Readings
-
Umumiy pedagogika va psixologiya
- 2025-11-22 11:24:31
- 321 Views
- 0 Readings
-
-

-
Umumiy pedagogika : darslik
- 2025-12-02 14:36:59
- 436 Views
- 0 Readings
-
Umumiy pedagogika va psixologiya
- 2025-12-02 16:13:53
- 402 Views
- 0 Readings
-

Umumiy va sport psixologiyasi
- 2026-01-06 09:52:00
- 229 Views
- 0 Readings
-
UMURTQALILAR ZOOLOGIYASI
- 2026-01-07 11:04:39
- 218 Views
- 0 Readings
-
UMURTQALILAR ZOOLOGIYASI
- 2026-01-07 11:05:39
- 230 Views
- 0 Readings
-
UMURTQALILAR ZOOLOGIYASI Laboratoriya mashgʻulotlari
- 2026-01-07 11:07:28
- 286 Views
- 0 Readings
-
UMUMIY ENTOMOLOGIYA VA ZOOLOGIYA
- 2026-01-07 11:12:42
- 280 Views
- 0 Readings
-

Umumiy pedagogika
- 2026-01-09 09:25:43
- 222 Views
- 0 Readings
-
Umumiy pedagogika va psixologiya
- 2026-01-09 15:28:28
- 203 Views
- 0 Readings
-
Umurtqasizlar zoologiyasi fanidan amaliy mashg'ulotlar.
- 2026-01-10 10:36:00
- 236 Views
- 0 Readings
-
UMUMIY ENTOMOLOGIYA VA ZOOLOGIYA
- 2026-01-10 10:40:51
- 213 Views
- 0 Readings
-

Umumiy astronomiya
- 2026-01-12 13:50:06
- 224 Views
- 0 Readings
-

Umumiy psixologiya
- 2026-01-16 09:11:48
- 277 Views
- 0 Readings
-

Umumiy pedagogika
- 2026-01-16 10:12:47
- 282 Views
- 0 Readings
-

UMUMIY KIMYO
- 2026-01-16 15:59:12
- 193 Views
- 0 Readings
-

Umurtqalilar zoologiyasidan laboratoriya mashg`ulotlari
- 2026-01-16 16:35:45
- 220 Views
- 0 Readings
-
Umumiy pedagogika (Pedagogika tarixi)
- 2026-01-17 10:23:56
- 203 Views
- 0 Readings
-

Umumiy pedagogika
- 2026-01-21 14:34:51
- 229 Views
- 0 Readings
-
Umumiy pedagogika
- 2026-01-22 10:08:53
- 323 Views
- 0 Readings
-

UMUMIY MIKROBILOGIYA
- 2026-01-26 09:24:45
- 239 Views
- 0 Readings
-
UMUMIY PEDAGOGIKA
- 2026-01-26 10:57:29
- 248 Views
- 0 Readings
-
Umumiy Pedagogika
- 2026-01-26 10:58:45
- 208 Views
- 0 Readings
-

Umumiy fizika. Atom va yadro fizikasidan masalalar to'plami
- 2026-01-27 10:43:42
- 233 Views
- 0 Readings
-
Umumiy pedagogika va psixologiya
- 2026-01-28 09:56:25
- 216 Views
- 0 Readings
-
Umumiy pedagogika nazariyasi va amaliyoti
- 2026-02-05 15:58:25
- 306 Views
- 0 Readings
-

Umumiy psixologiya.
- 2026-02-07 11:00:32
- 250 Views
- 0 Readings
-
-

Umumiy pedagogika (pedagogik mahorat)
- 2026-02-09 15:18:43
- 218 Views
- 0 Readings
-
Umumiy psixologiya va pedagogika II qism
- 2026-02-09 15:40:08
- 223 Views
- 0 Readings
-

-

Umumiy pedagogika
- 2026-02-14 09:21:10
- 288 Views
- 0 Readings
-
Umumiy pedagogika
- 2026-02-14 09:55:02
- 301 Views
- 0 Readings
-

-

Umumiy pedagogika
- 2026-02-16 10:28:53
- 233 Views
- 0 Readings
-
UMURTQALILAR ZOOLOGIYASI
- 2026-02-16 10:40:14
- 240 Views
- 0 Readings
-
UMUMIY PEDAGOGIKA
- 2026-02-18 09:48:15
- 200 Views
- 0 Readings
-

Umumiy fizika (Atom, yadro va elemtar zarralar fizikasi)
- 2026-02-19 10:22:27
- 223 Views
- 0 Readings
-
Umumiy pedagogika
- 2026-02-20 09:03:50
- 230 Views
- 0 Readings
-
Umumiy pedagogika nazariyasi va amaliyoti
- 2026-02-21 11:07:50
- 275 Views
- 0 Readings
-
UMUMIY PEDAGOGIKA
- 2026-02-21 11:08:32
- 239 Views
- 0 Readings
-

Umumiy pedagogika
- 2026-02-23 15:14:01
- 260 Views
- 0 Readings
-

-

-

Umumiy psixologiya
- 2026-03-03 10:00:19
- 215 Views
- 0 Readings
-
Umumiy psixologiya va pedagogika II qism
- 2026-03-03 15:54:51
- 292 Views
- 0 Readings
-

Umumiy psixologiya
- 2026-03-06 09:44:00
- 227 Views
- 0 Readings
-
Umumiy psixologiya va pedagogika II qism
- 2026-03-10 15:18:22
- 196 Views
- 0 Readings
-
Umumiy psixologiya va pedagogika II qism
- 2026-03-11 09:46:33
- 151 Views
- 0 Readings
-

UMUMIY PSIXODIAGNOSTIKA
- 2026-03-11 09:55:42
- 233 Views
- 0 Readings
-
Umumiy pedagogika
- 2026-03-12 09:26:05
- 189 Views
- 0 Readings
-
UMUMIY PEDAGOGIKA
- 2026-03-13 09:20:44
- 246 Views
- 0 Readings
-

Umumiy pedagogika nazariyasi va amaliyoti
- 2026-03-18 16:27:32
- 231 Views
- 0 Readings
-

Uvaysiy Nodira 10-jild
- 2026-03-19 09:10:45
- 165 Views
- 0 Readings
-

Umumiy tabiiy geografiya
- 2026-03-19 09:30:17
- 234 Views
- 0 Readings
-

UMUMIY FIZIKA
- 2026-03-19 12:04:55
- 209 Views
- 0 Readings
-
Umumiy psixologiya va pedagogika II qism
- 2026-03-23 15:22:00
- 165 Views
- 0 Readings
-
UMURTQALILAR ZOOLOGIYASI
- 2026-03-23 15:30:00
- 307 Views
- 0 Readings
-

UMUMIY PEDAGOGIKA (pedagogika nazariyasi)
- 2026-03-25 09:59:35
- 245 Views
- 0 Readings
-
Umumiy psixologiya va pedagogika II qism
- 2026-04-06 09:17:43
- 176 Views
- 0 Readings
-

UMUMIY PEDAGOGIKA
- 2026-04-06 10:37:56
- 159 Views
- 0 Readings
-

Umumiy pedagogika
- 2026-04-15 09:17:58
- 217 Views
- 0 Readings
-

Umumiy pedagogika nazariyasi va amaliyoti
- 2026-04-15 09:34:55
- 96 Views
- 0 Readings
-

UNLOCK reading 8 writing skills.
- 2026-04-16 15:37:44
- 117 Views
- 0 Readings
-
Umumiy pedagogika va psixologiya
- 2026-04-17 10:14:53
- 83 Views
- 0 Readings
-

Umumiy fizikaning optika bo’limidan masalalar to’plami
- 2026-04-20 10:39:04
- 107 Views
- 0 Readings
-

Umumiy fizika fanidan masalalar to'plami
- 2026-04-21 09:51:59
- 87 Views
- 0 Readings
-

Umumiy tabiiy geografiya
- 2026-04-21 10:38:56
- 201 Views
- 0 Readings
-

Umumiy fizika kursidan praktikum
- 2026-04-22 09:14:58
- 78 Views
- 0 Readings
-
-

Umumiy fizikadan masalalar to'plami
- 2026-04-24 09:39:33
- 88 Views
- 0 Readings
-

UMUMIY ENTOMOLOGIYA VA ZOOLOGIYA
- 2026-04-27 10:36:07
- 73 Views
- 0 Readings
-

Umumiy mikrobiologiya
- 2026-04-27 11:10:09
- 86 Views
- 0 Readings
-

Umumiy fizika kursidan masalalar to`plami
- 2026-04-27 11:30:17
- 82 Views
- 0 Readings
-

UMURTQASIZLAR ZOOLOGIYASI
- 2026-04-27 13:21:25
- 96 Views
- 0 Readings
-

UMURTQALILAR ZOOLOGIYASI Laboratoriya mashgʻulotlari
- 2026-04-27 13:22:58
- 86 Views
- 0 Readings
-

UMUMIY PEDAGOGIKA
- 2026-04-28 09:55:02
- 74 Views
- 0 Readings
-
Umumiy pedagogika
- 2026-04-29 09:58:34
- 89 Views
- 0 Readings
-

Umumiy fizika kursidan praktikum
- 2026-05-06 09:24:38
- 94 Views
- 0 Readings
-

UNLOCK READING & WRITING SKILLS 4
- 2026-05-13 09:47:12
- 83 Views
- 0 Readings
-

Umumiy pedagogika nazariyasi va amaliyoti
- 2026-05-15 09:19:07
- 76 Views
- 0 Readings
-
UMUMIY TILSHUNOSLIK
- 2026-05-20 16:47:02
- 84 Views
- 0 Readings
-

UMUMIY PEDAGOGIKA NAZARIYASI VA AMALIYOTI
- 2026-06-01 11:24:39
- 92 Views
- 0 Readings
-

UMUMIY PEDAGOGIKA
- 2026-06-23 13:21:03
- 13 Views
- 0 Readings
-

Umumiy astronomiya
- 2026-06-25 15:09:43
- 32 Views
- 0 Readings
-

UZLUKSIZ TA’LIMDAGI TENDENSIYALAR VA ZAMONAVIY YONDASHUVLAR
- 2026-06-26 12:44:19
- 13 Views
- 1 Readings